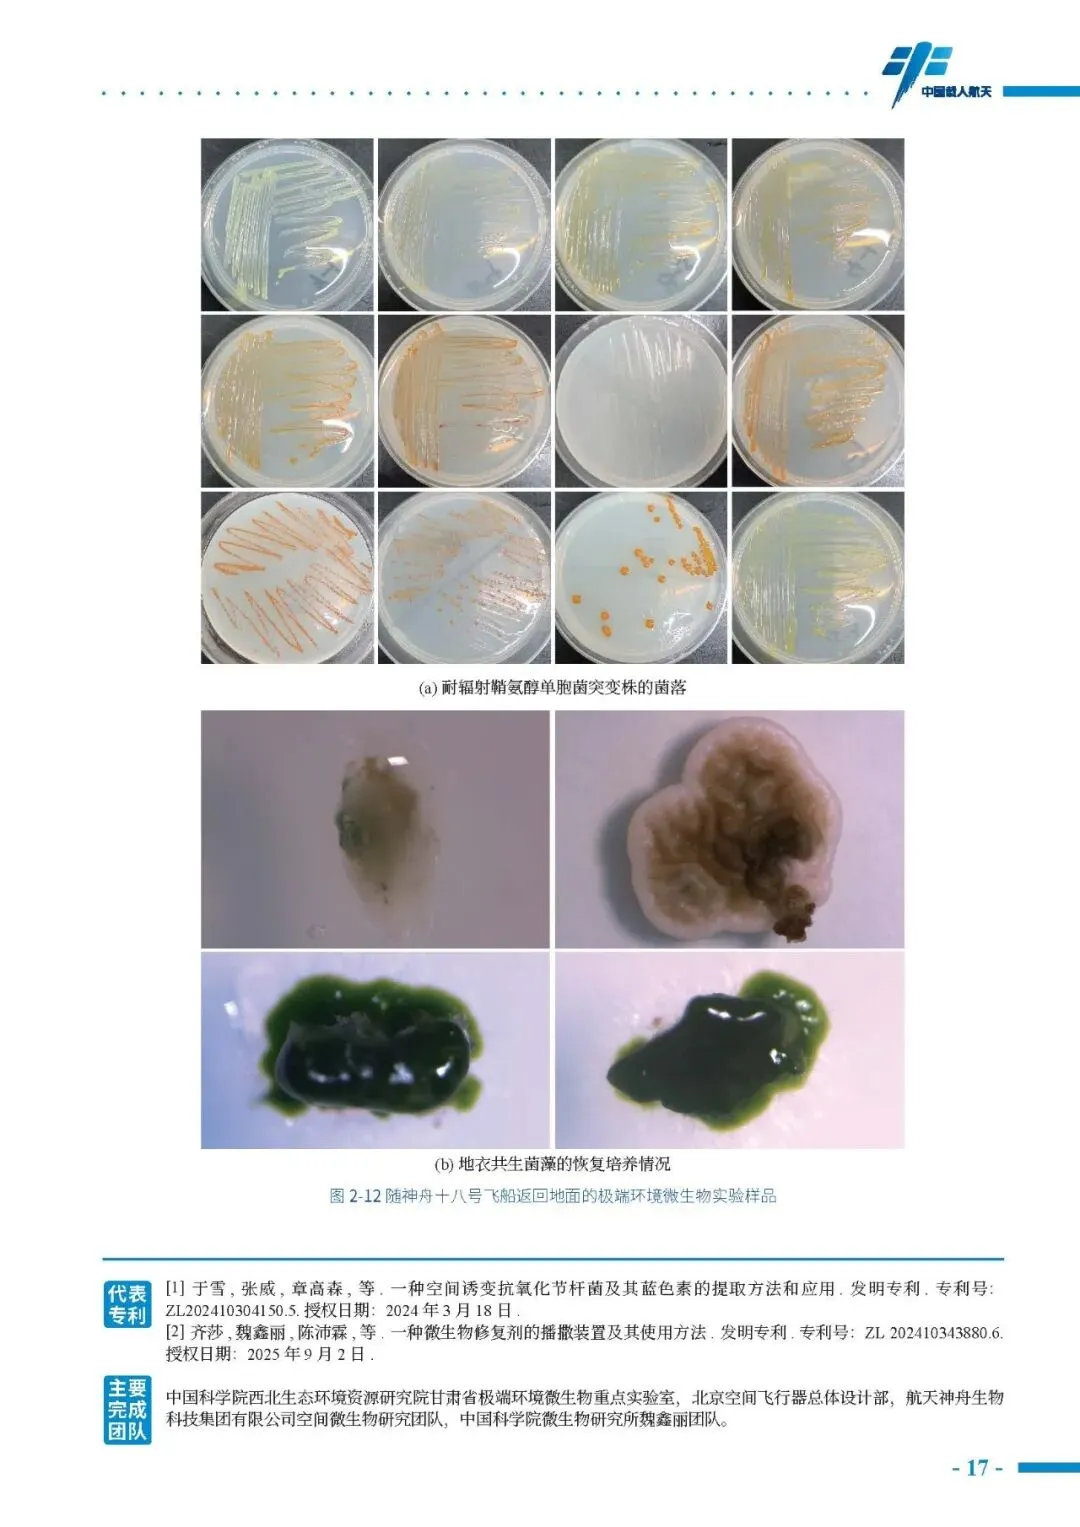

以下为报告部分内容:






























本报告共计:94页。受篇幅限制,仅列举部分内容。
如欲获取完成版PDF文件,关注公众号后,对话框中回复“yb-4945”。
本报告已上传知识星球,更多高质量报告,加入知识星球即可下载,知识星球链接:https://t.zsxq.com/iEqjaEu
温馨提示:有任何问题或合作可咨询微信号:15618543888,或扫描以下二维码添加微信好友~





以下为报告部分内容:

本报告共计:94页。受篇幅限制,仅列举部分内容。
如欲获取完成版PDF文件,关注公众号后,对话框中回复“yb-4945”。
本报告已上传知识星球,更多高质量报告,加入知识星球即可下载,知识星球链接:https://t.zsxq.com/iEqjaEu
温馨提示:有任何问题或合作可咨询微信号:15618543888,或扫描以下二维码添加微信好友~




